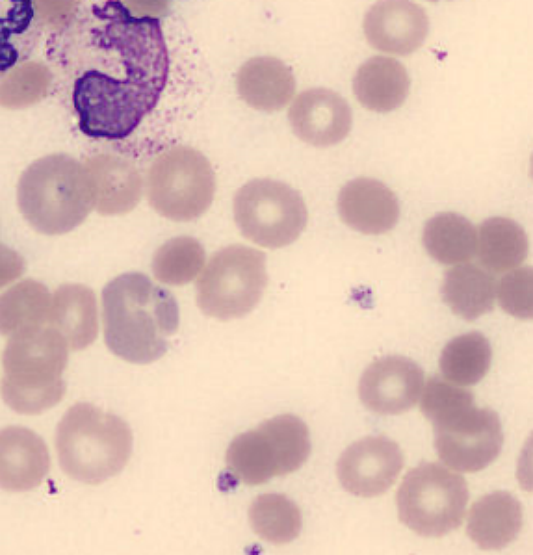
图片1.png

电话:029-87679000(总机)
地址:陕西省西安市西五路157号
邮编:710114
网址:www.2yuan.xjtu.edu.cn

电话:029-87679000(总机)
地址:陕西省西安市西五路157号
邮编:710114
网址:www.2yuan.xjtu.edu.cn

每周三下午是检验科业务学习时间,4月19日的会上首先由临检专业组张雯汇报了近期发现的一例罕见的巴贝斯虫感染病例。4月10日,检验科血液组在血涂片镜检过程中发现红细胞内含物疑似巴贝斯虫。查阅患者检查结果发现存在严重溶血性贫血,符合巴贝斯虫感染症状。临检组组长张磊随即联系感染科追问病情并告知该情况,随后多次联系临床参与病情讨论。
巴贝斯虫是一种红细胞内寄生虫,主要通过蜱叮咬传播。脾切除、老年、免疫缺陷等人群易表现出临床症状,出现溶血性贫血,伴蛋白尿、血尿和肾功能障碍等,严重者导致死亡。临床发现蜱虫叮咬史,应结合症状诊断是否可能为巴贝斯虫感染。克林霉素加奎宁治疗对该病有效,早期进行红细胞置换可降低寄生虫血症,减少病死率。该病例在我国只见30例左右的报道,我省未见报道。该患者因头晕、呕吐、乏力收治于感染科,患者两月前曾因乙肝肝硬化失代偿期合并自发性腹膜炎住院治疗。患者入院后发现严重的血管内溶血,虽经过多方积极协作抢救,患者仍于4月11日因多脏器功能衰竭死亡。患者血清标本已交由检测机构进行PCR检测以确定病原种属。
会上,科主任耿燕对临检组工作的认真负责进行了表扬和奖励,并要求大家在日常工作中应继续加强细胞形态学的学习和识别,加强与临床科室的及时沟通,做到检验报告的及时科学准确,为临床诊断提供第一手数据支持。业务学习后,科主任耿燕对科室近期工作进行了总结。
为积极响应新一轮医改降低检查费用的要求,我科室自4月1日起对所有检查项目执行新价格。为应对价格下调后收入减少的情况,严格控制运行成本,科室要求各专业组对所开展项目的试剂成本进行摸底调查,科室试剂耗材等进行专人专项管理,从各个方面杜绝浪费,并要求杜绝不规范的项目检查。此外,科室要求大家本着服务临床的态度,多借鉴先进经验,积极开展新项目,更好地服务于临床、服务于患者。

自住院部切换新HIS系统后,时有因条码执行问题造成患者出院手续无法完成的情况,为配合临床工作,更好地服务患者,科室要求执行第一负责人制度,如有临床要求执行医嘱,任何人不得以任何理由推诿。并要求全体科室成员严格执行条码,当日不能检测的检验项目,标本及时接收,对医生临时开具的口头医嘱必须补加条码。
最后,邀请保卫科专业人员对检验科所有人员进行消防知识专项培训。本次培训主要内容涉及消防灭火装置的使用及报警逃生流程。保卫科相关人员向大家讲解了消防水枪及灭火器的使用方法和以及应急状况下人员疏散、逃离注意事项。实验室生物安全和消防安全作为科室实验室管理的一项重要内容,科室质量控制小组对消防安全非常重视,要求大家严格执行实验室制度、流程和SOP,确保实验室生物安全和消防安全。